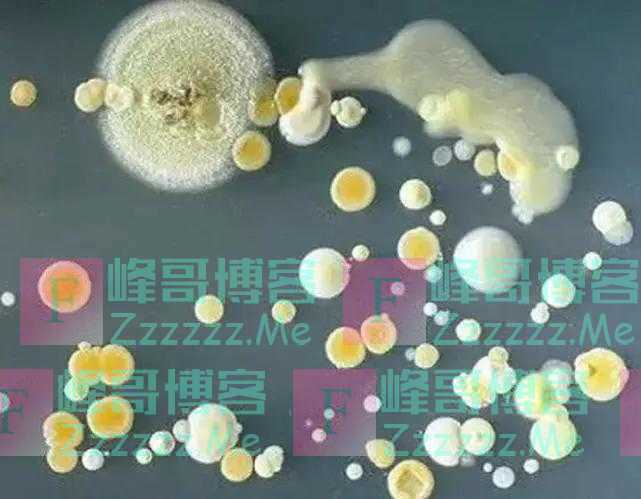

导语:科学家为长生不老,给自己注射350万年前的细菌,后来成功了吗?

长生不老,我想这个是很多人内心的愿望吧,因为人类的寿命其实说长不长,说短也不短。但是能够延长自己的寿命,我想应该没有人会拒绝。
而且从古代开始,有些一些人追求长生不老的药,就是为了追求寿命的极限,但是却没有成功的案例。而最疯狂的,就是当年这位科学家,给自己注射350万年前的细菌,只为长生不老。

其实这位科学家叫做阿纳托利·布鲁奇科,是一位俄罗斯莫斯科国立大学地质系的主任。他个人对于长寿这个东西,一直都是非常感兴趣的。
而且当年他在永久冻土层深处,发现了距今350万年的芽孢杆菌F。而且他对着细菌进行了一个细致的研究,居然发现其具有“永生”的能力。
原来芽孢杆菌F具有很强的修复能力,经过芽孢杆菌F感染之后的生物,生长速度是明显加快的。而且他还对当地的人们进行研究,发现他们的普遍寿命都比较长。
后来布鲁奇科还用小白鼠进行试验,发现芽孢杆菌F刺激了动物的生长,也增强了免疫系统,并且对人类红细胞和白细胞的实验也很乐观。所以布鲁奇科初步分析,这个芽孢杆菌F可能可以让人延长寿命,于是就果断给自己注射了芽孢杆菌F。

如今的布鲁奇科怎么样了呢?
布鲁奇科夫博士觉得自己身体好像比以前更好了,而且注射了这个细菌两年里,几乎没有得过流感。而且现在已经过去5年了,布鲁奇科夫还是很健康。而且他觉得, 就是因为注入了芽孢杆菌F之后,使得细胞的注入了新的活力,免疫力也得到了增强。至于有没有副作用,现在还不得而知。
【注:本文为作者“微国际”原创,未经授权,任何商业不得转载。图片来源于网络,如有版权方请联系删除】
文章如无特别注明均为原创!
作者:
F_Robot,
转载或复制请以
超链接形式 并注明出处 峰哥博客。
原文地址《
科学家为长生不老,给自己注射350万年前的细菌,后来成功了吗》发布于2020-3-16
若您发现软件中包含弹窗广告等还请第一时间留言反馈!
小米手机无法安装请到设置->开发者设置->关闭系统优化,安装后再开启系统优化。
